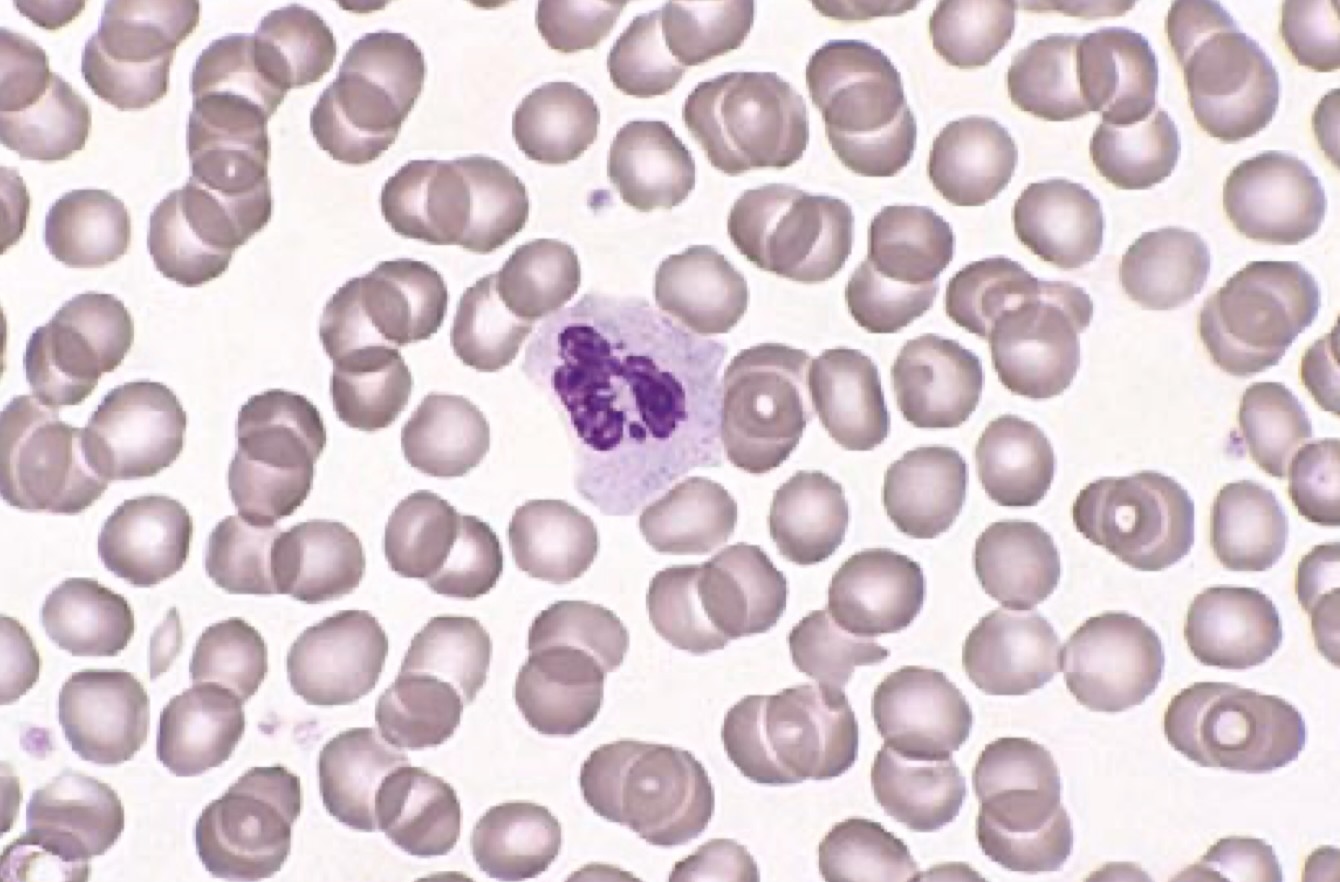
آموزش دیف هماتولوژی
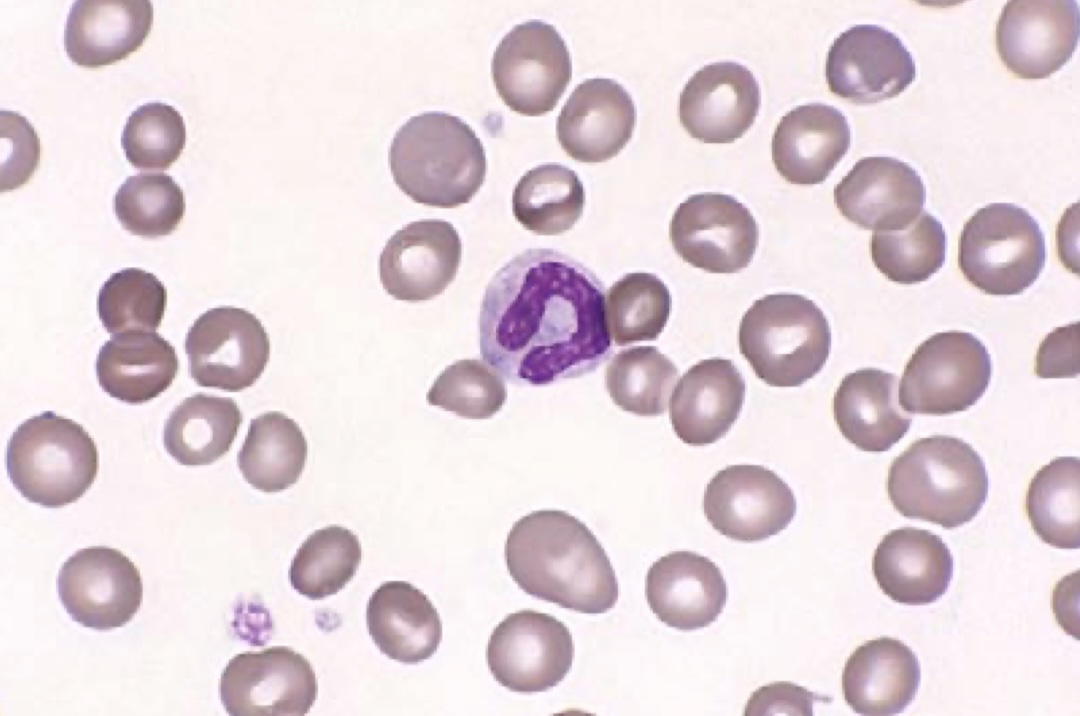
آموزش دیف هماتولوژی
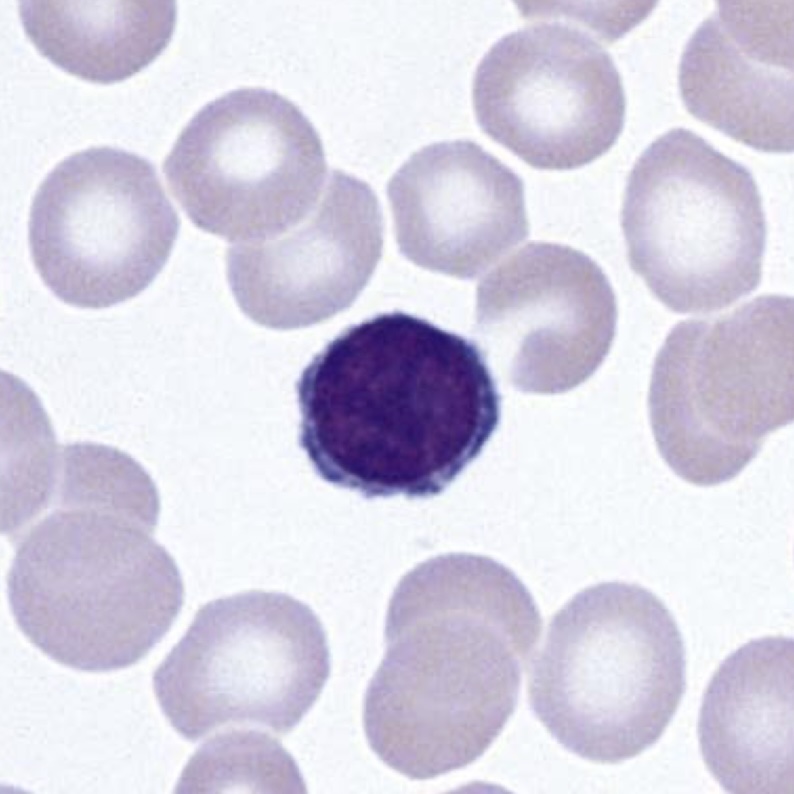
آموزش دیف هماتولوژی
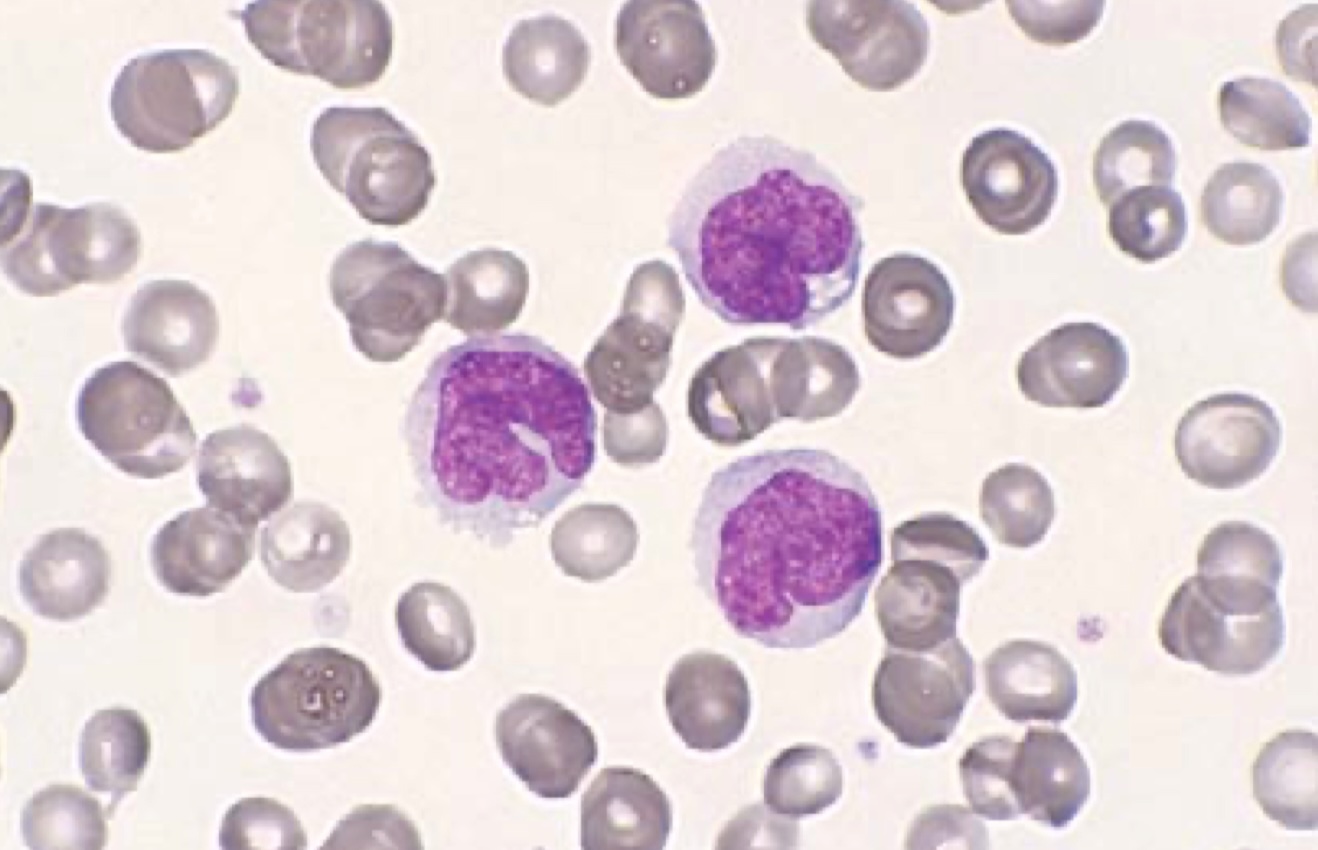
آموزش دیف هماتولوژی
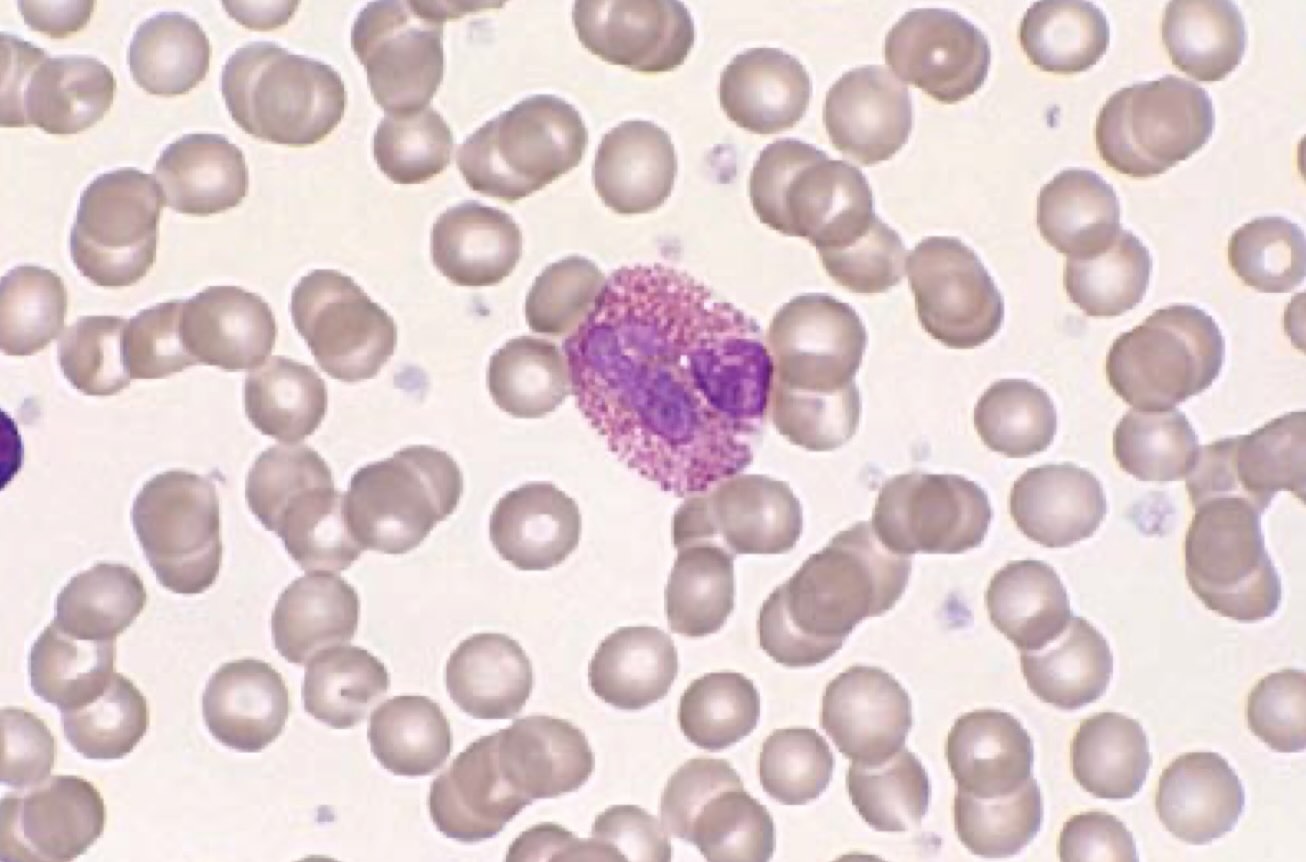
ائوزینوفیل

آموزش دیف هماتولوژی برای کارشناسان آزمایشگاه
آموزش دیف هماتولوژی شامل آشنایی با فیزیولوژی لکوسیتها، نحوه تهیه و رنگآمیزی اسمیر خون محیطی، بررسی میکروسکوپی سلولهای خونی، تفسیر دیف دستی و کنترل کیفی نتایج است. در این راهنما، مراحل انجام دیف، خطاهای شایع و نکات تخصصی برای کارشناسان آزمایشگاه بهصورت گامبهگام توضیح داده میشود.
جهت عضویت در کانال آموزشی هماتولوژی در تلگرام به لینک زیر مراجعه کنید:
https://t.me/hematology_education
فهرست مطالب آموزش دیف هماتولوژی
هدف و اهمیت انجام دیف هماتولوژی
فیزیولوژی لکوسیتها و نقش آن در دیف هماتولوژی
مراحل انجام دیف هماتولوژی (نمونهگیری تا شمارش)
روشهای رنگآمیزی اسمیر در آموزش دیف هماتولوژی
بررسی میکروسکوپی و ناحیه مناسب برای دیف
معرفی مورفولوژی سلولها در دیف هماتولوژی
محدوده نرمال انواع سلولهای سفید
تفسیر نتایج دیف و الگوهای غیرطبیعی
خطاهای شایع در دیف هماتولوژی
کنترل کیفی در دیف هماتولوژی
نکات تخصصی و تجربی برای کارشناسان
جمعبندی نهایی
سوالات متداول درباره آموزش دیف هماتولوژی
منابع معتبر برای مطالعه بیشتر
مقدمه: آموزش دیف هماتولوژی برای کارشناسان آزمایشگاه
دیف هماتولوژی (Differential Count) یکی از مهمترین و پایهایترین آزمونها در بخش هماتولوژی آزمایشگاههای تشخیص طبی است. در این روش، انواع سلولهای سفید خون (WBCs) در اسمیر خون محیطی بررسی و درصد هر نوع سلول تعیین میشود.
نتیجه این آزمایش نقش حیاتی در تشخیص بسیاری از بیماریهای خونی، التهابی، عفونی و بدخیمیهای مغز استخوان دارد. با وجود توسعه دستگاههای اتوماتیک شمارش سلولی، مهارت در انجام دیف دستی همچنان جزء ارکان اصلی صلاحیت حرفهای کارشناسان آزمایشگاه محسوب میشود.
در دیف دستی، علاوه بر شمارش سلولها، ویژگیهای مورفولوژیک گلبولهای سفید، قرمز و پلاکتها نیز بررسی میشود. این بررسی دید جامعی از وضعیت هماتوپوئز و شرایط فیزیولوژیک یا پاتولوژیک بیمار فراهم میکند.
هدف و اهمیت انجام دیف هماتولوژی در آموزش عملی هماتولوژی
هدف اصلی دیف، تعیین نسبت و کیفیت انواع لکوسیتها در خون محیطی است.
اما در واقع، این آزمون فراتر از یک شمارش ساده بوده و بخشی از ارزیابی کلی سلولهای خونی است.
کارشناسان با انجام دقیق دیف میتوانند تغییرات ظریف سلولی را شناسایی کنند که دستگاههای خودکار قادر به تشخیص آنها نیستند.
اهمیت بالینی دیف هماتولوژی:
- شناسایی سلولهای نابالغ (Blasts) در تشخیص لوسمیها
- تمایز میان عفونتهای باکتریایی، ویروسی، انگلی و آلرژیک
- بررسی پاسخ مغز استخوان به کمخونیها یا داروها
- تشخیص نوتروفیلیای واکنشی در برابر نوتروفیلیای نئوپلاستیک
- شناسایی تغییرات سمی (toxic changes) در نوتروفیلها
- ارزیابی وضعیت سیستم ایمنی از طریق نسبت نوتروفیل به لنفوسیت
فیزیولوژی لکوسیتها و اهمیت آن در آموزش دیف هماتولوژی
لکوسیتها (گلبولهای سفید) گروهی از سلولهای خونی هستند که در دفاع ایمنی بدن نقش دارند. این سلولها در مغز استخوان ساخته شده و از طریق خون به بافتهای مختلف منتقل میشوند.
پنج نوع اصلی لکوسیت وجود دارد که هر کدام وظایف ویژهای در ایمنی بدن دارند:
۱. نوتروفیلها (Neutrophils)
سلولهای چندلوبه با گرانولهای ریز بنفش که در دفاع علیه باکتریها نقش اصلی دارند.
نیمهعمر کوتاهی دارند و در التهابهای حاد افزایش مییابند.
۲. لنفوسیتها (Lymphocytes)
سلولهایی با هسته مدور و سیتوپلاسم کم، که شامل زیرگروههای B و T هستند.
در ایمنی اختصاصی نقش کلیدی دارند.
۳. مونوسیتها (Monocytes)
سلولهای بزرگ با هسته لوبیاییشکل و سیتوپلاسم خاکستری.
در بافتها به ماکروفاژ تبدیل میشوند.
۴. ائوزینوفیلها (Eosinophils)
دارای هسته دو لوبی و گرانولهای درشت نارنجی هستند.
در واکنشهای آلرژیک و عفونتهای انگلی نقش دارند.
۵. بازوفیلها (Basophils)
کمتعدادترین نوع لکوسیت با گرانولهای آبی تیره هستند.
حاوی هیستامین و هپارین بوده و در پاسخهای آلرژیک شدید فعال میشوند.
مراحل انجام دیف هماتولوژی از نمونهگیری تا شمارش
۱. نمونهگیری
نمونه خون باید در لوله حاوی ضدانعقاد EDTA جمعآوری شود.
استفاده از نمونهی تازه (حداکثر تا دو ساعت پس از خونگیری) ضروری است، زیرا ماندگاری طولانی باعث تخریب سلولها و تغییر در مورفولوژی میشود.
۲. تهیه اسمیر خون محیطی
تهیه اسمیر با لام تمیز و خشک انجام میشود.
یک قطره کوچک از خون را در فاصله حدود ۱ سانتیمتر از انتهای لام قرار دهید. لام پخشکننده را با زاویه ۳۰ تا ۴۵ درجه روی لام قرار دهید و با حرکت یکنواخت آن را به جلو بکشید تا لایهای نازک از خون تشکیل شود.
اسمیر باید سه ناحیه مشخص داشته باشد:
- بخش ضخیم (نزدیک محل قرارگیری قطره)
- بخش مناسب یا Feather Edge برای بررسی سلولی
- بخش نازک در انتهای اسمیر
کیفیت مناسب اسمیر:
ضخامت یکنواخت، بدون خطوط یا حباب، و انتهای نازک و تدریجی.
تصویر یک اسمیر مناسب را در زیر مشاهده میکنید.
۳. رنگآمیزی اسمیر
رنگآمیزی مناسب کلید اصلی مشاهده دقیق سلولها است. سه روش متداول رنگآمیزی عبارتاند از:
الف) رنگ Wright
رنگ Wright حاوی متیلن بلو و ائوزین است. رنگ هسته را آبی و سیتوپلاسم را صورتی رنگ میکند.
زمان رنگآمیزی حدود ۱۰ دقیقه است.
ب) رنگ Giemsa
دارای ترکیب پیچیدهتر با توان تفکیک بالاتر برای بررسی جزئیات هسته و گرانولها است.
زمان رنگآمیزی بین ۱۵ تا ۲۰ دقیقه است.
ج) رنگ Wright–Giemsa
ترکیب دو رنگ فوق برای رنگآمیزی عمومیترین کاربرد را دارد و تعادل رنگی مناسبی میان سیتوپلاسم و هسته ایجاد میکند.
نکات مهم رنگآمیزی:
- استفاده از متانول تازه برای فیکس کردن اسمیر
- رعایت pH محلول بافر (۷٫۲ تا ۷٫۴)
- شستوشوی ملایم برای جلوگیری از کمرنگ شدن سلولها
تصویر رنگآمیزی صحیح اسمیر را در زیر مشاهده میکنید.
۴. بررسی میکروسکوپی
اسمیر را ابتدا در بزرگنمایی ×10 بررسی کنید تا کیفیت رنگآمیزی، توزیع سلولها و ناحیه مناسب مشخص شود.
سپس در بزرگنمایی ×100 (با روغن ایمرسیون) شمارش سلولها آغاز میشود.
منطقه مناسب برای شمارش، ناحیه feather edge است که سلولها بهصورت یکنواخت و جدا از هم دیده میشوند.
روش شمارش:
- ۱۰۰ سلول سفید را شمارش کرده و نوع هر یک را ثبت کنید.
- در موارد خاص (مانند حضور سلولهای نابالغ یا شمارش پایین)، شمارش تا ۲۰۰ سلول نیز انجام میشود.
معرفی مورفولوژی سلولها در دیف هماتولوژی
نوتروفیل سگمانته
دارای هسته ۲ تا ۵ لوب متصل و سیتوپلاسم صورتی با گرانولهای ریز بنفش.
افزایش در عفونتهای باکتریایی و التهابها.
تصویر نوتروفیل سگمانته را در زیر مشاهده میکنید.
نوتروفیل
نوتروفیل باند
هسته نوارمانند بدون تقسیم واضح. نشانگر نوتروفیل نابالغ است.
افزایش آن بهصورت “شیفت به چپ” شناخته میشود.
تصویر نوتروفیل باند را در زیر مشاهده میکنید.
نوتروفیل باند
لنفوسیت
هسته گرد با کروماتین متراکم و سیتوپلاسم آبی کمرنگ.
در مونونوکلئوز عفونی لنفوسیتها واکنشی و بزرگ میشوند.
تصویر لنفوسیت نرمال را در زیر مشاهده میکنید.
لنفوسیت کوچک در خون محیطی
مونوسیت
سلولی بزرگ با هسته لوبیایی و سیتوپلاسم خاکستری همراه با واکوئل.
افزایش آن در عفونتهای مزمن مشاهده میشود.
تصویر مونوسیت را در زیر مشاهده میکنید.
مونوسیت
ائوزینوفیل
دارای هسته دو لوبی و گرانولهای درشت نارنجیرنگ.
افزایش در آلرژی، آسم و عفونت انگلی.
تصویر ائوزینوفیل را در زیر مشاهده میکنید.
ائوزینوفیل
بازوفیل
گرانولهای آبی تیره دارد که ممکن است هسته را بپوشانند.
در میلوپرولیفراتیوها افزایش مییابد.
تصویر بازوفیل را در زیر مشاهده میکنید.

بازوفیل در خون محیطی
محدوده نرمال انواع سلولهای سفید در دیف هماتولوژی
| نوع سلول | محدوده نرمال (%) |
|---|---|
| نوتروفیل سگمانته | 50 – 70 |
| نوتروفیل باند | 0 – 6 |
| لنفوسیت | 20 – 40 |
| مونوسیت | 2 – 10 |
| ائوزینوفیل | 1 – 4 |
| بازوفیل | 0 – 1 |
تفسیر نتایج دیف هماتولوژی و الگوهای غیرطبیعی
| الگو | یافته اصلی | تفسیر احتمالی |
|---|---|---|
| نوتروفیلی | افزایش نوتروفیلها | عفونت باکتریایی، التهاب، استرس |
| لنفوسیتوز | افزایش لنفوسیتها | عفونتهای ویروسی، سل، برونکیت مزمن |
| ائوزینوفیلی | افزایش ائوزینوفیلها | آلرژی، انگل، آسم |
| بازوفیلی | افزایش بازوفیلها | لوسمی میلوئید مزمن |
| مونوسیتوز | افزایش مونوسیتها | سل، مالاریا، بیماریهای التهابی |
| حضور بلاستها | سلولهای نابالغ | لوسمی حاد |
خطاهای شایع در دیف هماتولوژی و آموزش عملی
- استفاده از نمونه لختهشده یا کهنه
- اسمیر ضخیم یا نازک بیش از حد
- رنگآمیزی با pH نامناسب
- شمارش در ناحیه نامناسب لام
- اشتباه در تشخیص سلولهای نابالغ
- عدم یکنواختی در حرکت لام هنگام پخش خون
کنترل کیفی در دیف هماتولوژی و آموزش صحیح آن
کنترل کیفی بخشی جداییناپذیر از هر دیف دستی است و بهطور مستقیم بر اعتبار نتایج و آموزش دیف هماتولوژی در محیطهای آموزشی و بالینی اثر میگذارد.
کنترل کیفیت قبل از آزمایش
کنترل کیفیت قبل از انجام دیف شامل انتخاب و آمادهسازی مناسب نمونه و تجهیزات است:
- استفاده از نمونه تازه و بدون همولیز
- بررسی کیفیت لام و رنگ (شفاف، بدون آلودگی و رسوب)
- اطمینان از صحت بافر و pH مناسب در رنگآمیزی
برای آشنایی بیشتر با اصول کنترل کیفی رنگآمیزی گیمسا، میتوانید به مطلب
کنترل کیفی رنگ گیمسا در اسلایدهای خونی
در وبسایت Heamostica مراجعه کنید.
کنترل کیفیت حین آزمایش
در حین انجام دیف، رعایت نکات زیر ضروری است:
- شمارش در ناحیه مناسب (feather edge) و یکنواخت اسمیر
- انجام دیف توسط افراد ماهر و آموزشدیده
- استفاده از اسلایدهای مرجع نرمال و پاتولوژیک برای مقایسه
- ثبت نتایج در فرم مخصوص QC و مقایسه با نتایج قبلی بیمار در صورت امکان
کنترل کیفیت پس از آزمایش
کنترل کیفی پس از انجام دیف، بر تفسیر نهایی نتایج و همخوانی آن با سایر آزمونها تمرکز دارد:
- تأیید نتایج غیرنرمال توسط کارشناس ارشد یا متخصص هماتولوژی
- مقایسه نتایج دیف با پارامترهای دستگاه اتومات (مانند WBC، %Lymph، %Neut و …)
- بررسی روندهای غیرعادی در بیماران بستری (Trend Analysis)
برای مطالعه بیشتر درباره اصول کلی کنترل کیفی در هماتولوژی، پیشنهاد میشود مقاله
کنترل کیفی در بخش هماتولوژی آزمایشگاه
را نیز مطالعه کنید.
نکات تخصصی و تجربی در آموزش دیف هماتولوژی
- همواره از لام تمیز و خشک استفاده کنید.
- هرگز روی اسمیر خیس رنگ نپاشید.
- در هنگام بررسی، از نور با شدت متوسط استفاده شود تا جزئیات سلولها واضحتر دیده شود.
- برای یادگیری بهتر، هر روز چند اسمیر نرمال و غیرنرمال را مقایسه کنید.
- در صورت مشاهده سلولهای غیرمعمول (مانند بلاست، پلاسموسیت یا سلولهای Auer rod مثبت) حتماً در گزارش قید شود.
- در موارد تردید، تأیید مجدد توسط فرد دوم انجام شود.
جمعبندی نهایی آموزش دیف هماتولوژی
دیف هماتولوژی نهتنها یک آزمون، بلکه مهارتی کلیدی برای هر کارشناس هماتولوژی است.
با انجام صحیح تمام مراحل از تهیه اسمیر تا تفسیر نهایی، میتوان اطلاعات ارزشمندی درباره وضعیت سیستم خونساز و ایمنی بیمار به دست آورد.
تسلط بر مورفولوژی سلولها، شناخت خطاهای احتمالی، و رعایت کنترل کیفی از ارکان اصلی دقت در این آزمایش به شمار میرود.
سوالات متداول درباره آموزش دیف هماتولوژی
۱. دیف هماتولوژی چیست و چه کاربردی دارد؟
دیف هماتولوژی شمارش افتراقی انواع گلبولهای سفید خون در اسمیر خون محیطی است. این آزمون برای تشخیص عفونتها، بیماریهای خونی، بدخیمیهای مغز استخوان و ارزیابی وضعیت سیستم ایمنی کاربرد دارد.
۲. در آموزش دیف هماتولوژی چند سلول باید شمارش شود؟
بهطور معمول در دیف دستی ۱۰۰ سلول سفید شمارش میشود. در موارد خاص، مانند وجود سلولهای نابالغ یا نتایج مشکوک، میتوان شمارش را تا ۲۰۰ سلول افزایش داد.
۳. بهترین ناحیه برای انجام دیف روی اسمیر کدام است؟
ناحیه feather edge یا همان بخش میانی-میانی اسمیر که سلولها در آن بهصورت یکنواخت، بدون همپوشانی و با فاصله مناسب دیده میشوند، بهترین ناحیه برای انجام دیف است.
۴. تفاوت دیف دستی با دیف اتومات چیست؟
دیف اتومات توسط دستگاههای آنالایزر انجام میشود و سرعت و تکرارپذیری بالاتری دارد، اما در تشخیص برخی سلولهای غیرطبیعی دقت کمتری دارد. دیف دستی توسط کارشناس ماهر انجام شده و امکان تشخیص تغییرات ظریف مورفولوژیک را فراهم میکند.
۵. چه نوع خطاهایی بیشتر در دیف هماتولوژی دیده میشود؟
خطاهای شایع شامل استفاده از نمونه کهنه، تهیه اسمیر نامناسب، رنگآمیزی غلط، شمارش در ناحیه نامناسب و اشتباه در تشخیص سلولهای نابالغ است.
۶. چرا کنترل کیفی در آموزش دیف هماتولوژی اهمیت دارد؟
کنترل کیفی باعث میشود نتایج دیف قابل اعتماد، قابل تکرار و قابل مقایسه با سایر آزمونها باشد. این موضوع هم در آموزش هماتولوژی و هم در کار بالینی اهمیت حیاتی دارد.
۷. آیا میتوان فقط به نتایج دستگاه اتومات برای دیف اعتماد کرد؟
در بسیاری از موارد نتایج دستگاه قابل قبول است، اما در حضور پرچمهای هشدار، نتایج غیرطبیعی یا بیماران هماتولوژیک، دیف دستی توسط کارشناس ضروری است.
۸. چه زمانی لازم است دیف تکرار شود؟
در صورت مشاهده خطا در اسمیر، کیفیت نامناسب رنگآمیزی، تناقض بین نتایج CBC و دیف، یا تغییرات بالینی جدید در وضعیت بیمار، تکرار دیف توصیه میشود.
۹. آموزش دیف هماتولوژی برای دانشجویان چگونه باید انجام شود؟
آموزش باید بهصورت ترکیبی از تئوری (فیزیولوژی و مورفولوژی سلولها) و عملی (تهیه اسمیر، رنگآمیزی، کار با میکروسکوپ) باشد و از اسلایدهای نرمال و پاتولوژیک بهعنوان نمونه آموزشی استفاده شود.
۱۰. ارتباط دیف هماتولوژی با سایر آزمایشها مثل CBC چیست؟
دیف هماتولوژی مکمل CBC است. نتایج دیف باید در کنار پارامترهای کمی CBC مانند WBC، RBC، Hb، PLT و شاخصهای گلبولی تفسیر شوند تا تصویر کاملتری از وضعیت خونسازی و بیماری احتمالی بهدست آید.
منابع معتبر برای مطالعه بیشتر در زمینه دیف هماتولوژی
- کنترل کیفی رنگ گیمسا در اسلایدهای خونی – Heamostica
- کنترل کیفی در بخش هماتولوژی آزمایشگاه – Heamostica
- –ICSH Recommendations for Peripheral Blood Cell Morphological Features
- ICSH recommendations for the standardization of nomenclature and grading of peripheral blood cell morphological features – PubMed
“`
